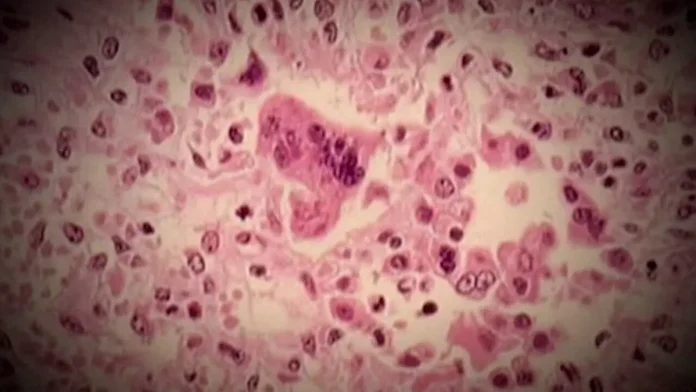

The province is warning the public about potential measles exposure at the Stollery Children’s Hospital.
In an advisory Tuesday, Alberta health officials said the potential exposures occurred on April 4 in various departments within the southwest Edmonton facility, including the emergency department.
Exposure locations are as follows:
-
Stollery Children’s Hospital Emergency Department waiting area, from 4:17 p.m. to 7:26 p.m.
-
Stollery Children’s Hospital emergency department M-Pod, from 3:26 p.m. – 10:16 p.m.
-
Stollery Children’s Hospital, X-ray department and waiting area, from 7:16 p.m. – 10:04 p.m.
The advisory notes that measles is an extremely contagious disease that spreads easily through the air.
Anyone who was in those areas of the hospital during the exposure times, who was born in or after 1970 and has fewer than two documented doses of measles-containing vaccine or has never had measles disease, may be at risk.
People who were exposed to the virus should monitor for symptoms of measles and are strongly encouraged to review their immunization records, the advisory said.
Symptoms of measles include: fever, cough, red eyes and a rash that appears three to seven days after fever starts, usually beginning behind the ears and on the face and spreading down to the body to the arms and legs.
The rash appears red and blotchy on lighter skin colours. On darker skin colours, it can appear purple or darker than the skin around it, and may be hard to see.
The alert is a among a series of exposure alerts issued across the province in recent weeks as new cases see an upswing
Provincial data shows the province has recorded 2,252 confirmed cases of measles since the current outbreak began more than a year ago.
Cases have been reported in all zones of the province, with the highest numbers in the north, south and central zones. Most reported cases have been in children under five years old and those aged five to 17 who are not immunized.